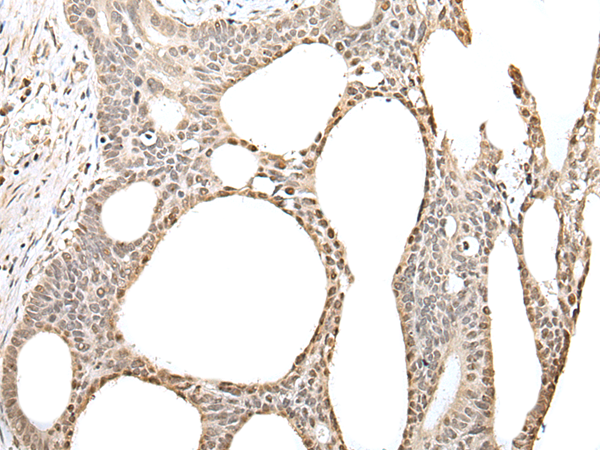

中文名稱:兔抗ZBTB5多克隆抗體
|
Background: |
Zinc finger and BTB domain-containing protein 5 (ZBTB5) is a 677 amino acid member of the Krüppel C2H2-type zinc-finger protein family. Localized to the nucleus, ZBTB5 contains a BTB domain, also known as a POZ domain, which inhibits DNA binding and mediates homotypic and heterotypic dimerization. Characteristics of the BTB domain suggest that ZBTB5 functions as a transcription regulator. |
|
Applications: |
ELISA, WB, IHC |
|
Name of antibody: |
ZBTB5 |
|
Immunogen: |
Fusion protein of human ZBTB5 |
|
Full name: |
zinc finger and BTB domain containing 5 |
|
SwissProt: |
O15062 |
|
ELISA Recommended dilution: |
5000-10000 |
|
IHC positive control: |
Human gastric cancer |
|
IHC Recommend dilution: |
30-150 |
|
WB Predicted band size: |
74 kDa |
|
WB Positive control: |
A431,K562 and TM4 cell lysates |
|
WB Recommended dilution: |
500-2000 |

購物車
購物車 幫助
幫助
 021-54845833/15800441009
021-54845833/15800441009
